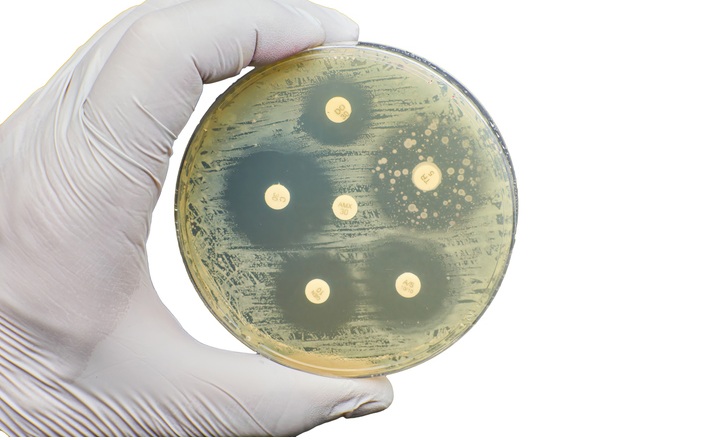
A case of resolving genotype phenotype AST discordance

Why This Matters:
- Limits of genotypic vs. phenotypic Antimicrobial Susceptibility Testing (AST): Molecular panels (e.g., BioFire FilmArray BCID2) can detect resistance genes directly from positive blood cultures, but gene detection doesn’t always correlate with phenotypic expression. Phenotypic tests can appear susceptible if the resistant subpopulation is very small or overgrown by susceptible cells.
- Mixed bacteremia challenges: Polymicrobial infections or mixed populations of MSSA Methicillin-Susceptible Staphylococcus aureus (MSSA) and Methicillin-Resistant S. aureus (MRSA) can confound both rapid molecular diagnostics and routine culture, potentially leading to under-detection of resistant subpopulations without careful adjudication.
- Adjudication strategies: When genotypic and phenotypic results disagree, ancillary tests such as subculture on chromogenic MRSA media, mannitol salt agar with cefoxitin discs, and PBP2a immunochromatographic assays can help reveal resistant subpopulations missed on initial phenotypic AST.
Key Findings: A 41-year-old woman with a history of MSSA bacteremia and spinal infection presented with wound dehiscence; blood cultures grew S. aureus.1 PCR directly from blood culture detected S. aureus, S. epidermidis, and both mecA/C and mecA/C + MREJ targets, leading to initiation of vancomycin treatment.
- Initial discordant results: Conventional phenotypic AST on subcultured S. aureus isolates using VITEK 2 and cefoxitin disc diffusion showed susceptibility to oxacillin/cefoxitin, inconsistent with the genotypic MRSA signal. PBP2a immunochromatographic testing on those colonies was negative.
- Adjudication to identify MRSA:
- Blood cultures were directly plated on chromogenic MRSA selective agar, yielding colonies suggestive of MRSA that were positive for PBP2a and oxacillin resistance (MIC > 4 µg/mL).
- On mannitol salt agar with a cefoxitin disc, small colonies appeared inside the inhibition zone, consistent with a minor MRSA subpopulation among predominantly MSSA growth.
- These findings confirmed mixed bacteremia with both MSSA and a small amount of MRSA that had been missed on routine subculture.
- Clinical impact: Correctly identifying the MRSA component influenced antibiotic therapy: prolonged vancomycin followed by dalbavancin was prescribed, and complete AST enabled planning for suppressive oral therapy in the setting of spinal hardware.
Bigger Picture: Rapid molecular AST panels are powerful tools but may produce results that do not align with phenotypic tests if resistant subpopulations are small or masked by more abundant susceptible organisms. Adjudication using selective culture media and PBP2a detection assays can uncover minor resistant populations, which is clinically important in severe infections such as S. aureus bacteremia. Laboratories should have protocols for resolving discordances between genotypic and phenotypic AST, guided by evidence and CLSI recommendations.
(Image Credit: iStock/ Nicolae Malancea)